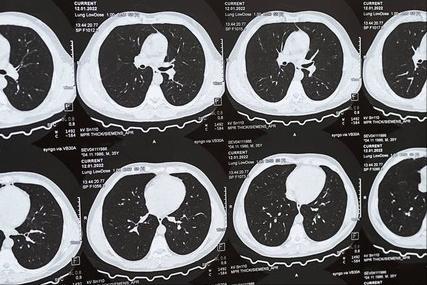
Image

薄层CT、增强CT、PET-CT,肺结节复查做哪个?教授:少花冤枉钱!
发布时间:2024-09-16
肺结节复查是早期发现肺癌的关键,但面对薄层CT、增强CT、PET-CT等多种检查方法,患者往往不知该如何选择。近日,一位肺结节患者在复查时发现结节略有增大,立即陷入恐慌,急于手术切除。然而,美国Lifespan癌症研究所胸部肿瘤科主任Christopher G. Azzoli博士给出的建议却是:继续观察,6个月后再复查。
这一案例凸显了肺结节复查的复杂性。那么,究竟应该如何选择合适的检查方法呢?
薄层CT是肺结节复查的首选方法。它具有高空间分辨率和成像快捷的优势,能够清晰显示肺结节的特征。根据中国肺部结节分类、诊断与治疗指南(2016年版),建议采用螺旋CT容积扫描技术,管电压100 KVp,管电流<40 mAs,总辐射暴露剂量≤5 mSv。扫描后原始数据行薄层重建,重建层厚为0.625 mm-1.25 mm。
增强CT主要用于鉴别结节的良恶性。通过注射造影剂观察病变组织的密度变化,可以进一步判断结节性质。但并非所有肺结节都需要做增强CT。江苏省中医院呼吸与危重症医学科主任周贤梅教授指出,直径>8 mm的实性结节或实性成分≥5 mm的混合磨玻璃结节,以及与肺血管关系密切或怀疑淋巴结转移者,建议行常规剂量增强CT检查。
PET-CT则是一种更高级的检查方法,主要用于评估结节的代谢活性。它结合了CT的解剖结构信息和PET的功能代谢信息,能够更准确地判断结节的良恶性。然而,PET-CT并非适用于所有肺结节患者。周贤梅教授建议,对于难以确定性质的结节,可以考虑PET-CT检查。
那么,不同大小和类型的肺结节应该如何选择检查方法呢?根据2024年《直径≤2cm肺结节胸外科合理诊疗中国专家共识》,对于直径<6 mm的纯磨玻璃结节(pGGN),建议年度复查肺部高分辨率CT(HRCT)。对于直径<6 mm的混合磨玻璃结节(mGGN),同样建议年度复查肺部HRCT。对于直径<6 mm的低危实性结节,建议年度随访肺部CT。而对于直径<6 mm的高危实性结节,则建议3个月复查肺部HRCT。
对于直径6-10 mm的结节,建议3个月复查肺部HRCT。如果随访后结节无明显变化,建议每半年复查肺部HRCT;如果随访后结节进展,则建议手术治疗或每3个月复查肺部HRCT。
对于直径10-20 mm的结节,建议3-6个月复查肺部HRCT。如果复查后无明显变化或进展,建议手术治疗或每3-6个月复查肺部HRCT;如果复查后进展,则建议手术治疗或PET-CT等手段进一步评估。
值得注意的是,肺结节复查并非一成不变。Azzoli博士指出,即使是恶性的磨玻璃结节,由于生长缓慢,6个月的观察期通常不会影响患者的预后。因此,是否需要立即手术,还需要结合患者的具体情况综合判断。
此外,定期随访对于肺结节患者至关重要。周贤梅教授强调,肺结节复查多数是对良性病灶而言的,关键在于动态观察。一般发现肺结节,需要进行薄层CT或薄层高分辨CT扫描,以便更好地显示肺结节的特征,并与既往历史影像学资料进行对比。
总的来说,肺结节复查应该遵循个性化原则,根据结节的大小、类型、生长速度以及患者的具体情况来选择合适的检查方法。同时,定期随访、动态观察是肺结节管理的关键。正如Azzoli博士所说,对于肺结节患者,避免不必要的手术损伤,选择合适的手术时机和术式,才能在未来的很长时间内享受到更高质量的生活。